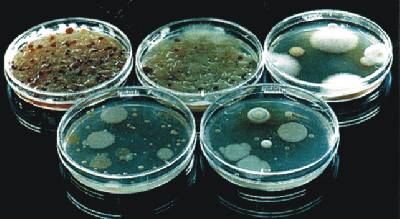

| VII: Biotechnologie (INHALT) |
 |
Gewinnung natürlicher Inhaltsstoffe aus Mikroorganismen | LOWRES 16 kbyte |
|

|
|
WIRKORT |
(B)akterien (P)ilze |
Antibiotikum |
hemmt oder beeinflußt |
|
Zellwand |
B P P |
Penicillin, Cephalosporin Polyoxin, Nikkomycin Papulacandin |
Mureinsynthese Chitinsynthese b -Glucansynthese |
|
Plasma-membran |
B P |
Polymyxin, Gramicidin Amphotericin B |
Erhöhung der Permeabilität Funktion der Membran |
|
Protein- biosynthese |
B P |
Streptomycin,Erythromyc. Cycloheximid |
Funktion der Ribosomen Funktion der Ribosomen |
|
DBA- Biosysnthese |
B P |
Anthracyclin, Bleomycin 5-Fluoruracil |
Thymidylat-Synthese |
|
RNA- Biosynthese |
B |
Rifamycin |
|
|
Kern |
P |
Griseofulvin |
Kernteilung |